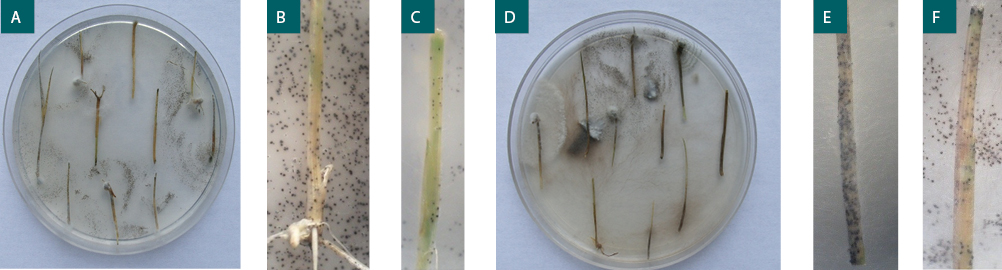
Figura 1

Artículos
Eficiencia de transmisión de Trichoconiella padwickii a coleoptilos de arroz en distintos sustratos
Eficiencia de transmisión de Trichoconiella padwickii a coleoptilos de arroz en distintos sustratos
RIA. Revista de Investigaciones Agropecuarias, vol. 47, núm. 3, pp. 376-379, 2021
Instituto Nacional de Tecnología Agropecuaria

Esta obra está bajo una Licencia Creative Commons Atribución-NoComercial 4.0 Internacional.
Recepción: 11 Agosto 2020
Aprobación: 03 Junio 2021
Publicación: 01 Diciembre 2021
Resumen: El hongo Trichoconiella padwickii es uno de los principales patógenos de la semilla de arroz en la provincia de Corrientes, Argentina. Con el objetivo de cuantificar la eficiencia de transmisión (Et) desde la semilla a coleoptilos de arroz se realizó un ensayo in vivo, utilizando semillas de las variedades Taim, Puitá INTA-CL e Irga 424. Las semillas se sembraron en bandejas plásticas que contenían arena estéril, papel y una mezcla de arena: tierra 1:1 como sustrato. Las bandejas se incubaron en laboratorio en condiciones de 25 ± 2 ºC y fotoperiodo de 12 h. La Et se evaluó a los siete días, sobre coleoptilos sembrados en medio agar poroto 3%. El patógeno presentó valores de Et desde 0,67 a 30,04% en función de la interacción sustrato-variedad. Estos resultados demuestran la importancia de la semilla como fuente de inóculo primario y la necesidad de establecer medidas de control.
Palabras clave: semilla, Oryza sativa, hongo.
Abstract: Trichoconiella padwickii is one of the most important fungi of rice seed in the province of Corrientes, Argentina. In order to quantify the transmission efficiency (Et) from the seed to rice coleoptiles, an “in vivo” test was carried out, using seeds of the varieties Taim, Puitá INTA-CL and Irga 424. The seeds were sown in trays plastics containing sterile sand, paper and a 1: 1 sand: soil mixture as substrate. The trays were incubated in the laboratory under conditions of 25 ± 2ºC and 12 h photoperiod. Et was evaluated at seven days, on coleoptiles plated in 3 % bean agar medium. Transmission efficiency values from 0.67 to 30.04% depending on the substrate-variety interaction. These results demonstrate the importance of the seed as a source of primary inoculum, and the need to establish control measures.
Keywords: seed, Oryza sativa, fungus.
INTRODUCCIÓN
La semilla de arroz (Oryza sativa L.) procedente de la provincia de Corrientes, Argentina, es portadora de hongos patógenos que producen enfermedades de importancia en la región; entre estos se destaca Trichoconiella padwickii (D. Ganguly) DL Jain (syn Alternaria padwickii (Ganguly) M.B. Ellis), que infecta a las semillas de arroz ocasionando decoloración, podredumbre de semillas y tizón de plántulas, manchas en hojas y granos de la panoja en cultivos de la provincia de Corrientes (Gutiérrez y Cúndom, 2008; Gutiérrez et al., 2010a).
Investigaciones realizadas a nivel mundial refieren a T. padwickii como uno de los principales patógenos de la semilla de arroz (Ou et al., 1985 Mathur et al., 1972; Costa, 1991; Islam et al., 2000; Farias et al., 2007; Suryadi y Kadir, 2009; Islam et al., 2012; Serferbe Signaboubo et al., 2016; Sultana et al., 2018; Nallathambi et al., 2019). Asimismo, la infección que ocurre en la semilla da como resultado la decoloración del grano, lo cual afectará posteriormente su calidad, y reduce la germinación en condiciones de campo (Mew y Misra, 1994 Mew y Gonzales, 2002; CABI, 2020).
Durante las campañas agrícolas 2008-2019 los análisis sanitarios realizados a semillas de arroz de la provincia de Corrientes registraron niveles de incidencia de T. padwickii superiores al 50% y una prevalencia del 100% (Gutiérrez et al., 2010b; Lovato y Gutiérrez, 2012; Dirchwolf et al., 2015; Lovato et al., 2020), lo cual explica que la semilla constituye la principal fuente de inóculo primario para el desarrollo de síntomas en hojas y granos de la panoja en cultivos de la región.
Según lo expresan Mew y Gonzales (2002), es necesario considerar la transmisión de los patógenos presentes en las semillas en relación con el establecimiento de la enfermedad en el cultivo, y los efectos consiguientes en la producción. Al respecto, Castaño Zapata (1985) afirma que la transmisión de patógenos por la semilla es reconocida como un método eficiente mediante el cual estos organismos son introducidos a áreas nuevas, sobreviven periodos durante los cuales el cultivo está ausente, y son distribuidos a través de poblaciones de plantas como focos de infección. Asimismo, es necesario considerar que no todos los patógenos transportados por la semilla de arroz, pueden pasar a la plántula; la eficiencia de transmisión varía de un organismo a otro y debe ser demostrada y cuantificada (Mew y Gonzales, 2002).
En relación con la transmisión de patógenos por semillas, se mencionan algunos ejemplos de estudios realizados; Domínguez y Grabowski (2017) cuantificaron la transmisión de Stenocarpella maydis y Colletotrichum gramincicola a coleoptilos de maíz y observaron una eficiencia de 79,5%, mientras que Castaño-Zapata (1985) estudió el efecto del manchado del grano por Bipolaris oryzae en la germinación y sobre la altura de las plántulas de arroz, y demostró que existía una reducción del 40% en ambas variables. Asimismo, Pineda et al. (2007) analizaron diferentes niveles de inóculo en semillas de arroz y demostraron que valores mayores a 0,1% de incidencia de B. oryzae ocasionan altas tasas de infección de plantas adultas, en campos productivos.
Con respecto a la transmisión de T. padwickii en Argentina, Gutiérrez (2010) y Lovato et al. (2013) observaron que este hongo se transmite de manera eficiente asintomática y sintomáticamente, desde semillas infectadas a coleoptilos de arroz. Es así que Gutiérrez (2010) evaluó la transmisión del patógeno en sustrato arena y tierra y determinó que se transmite hacia la parte aérea de plántulas de arroz a los 7, 11, 20 y 30 días después de la siembra, con diferentes valores. Además, al utilizar arena estéril como sustrato, comprobó que favoreció la manifestación de síntomas en las plántulas mientras que, utilizando tierra como sustrato, la transmisión fue asintomática. En tanto, Lovato et al. (2013) determinaron una Et de 7 a 28,5% al utilizar arena estéril para cuantificar la transmisión. Con el fin de aportar más información sobre el tema, el presente trabajo propone evaluar el efecto de diferentes sustratos sobre la Et de T. padwickii desde la semilla a coleoptilos de arroz.
MATERIALES Y MÉTODOS
El ensayo fue conducido en el laboratorio de Fitopatología de la Facultad de Ciencias Agrarias Universidad Nacional del Nordeste, Corrientes (Argentina). Se utilizaron semillas de arroz de las variedades Taim, Puitá INTA CL e Irga 424, procedentes del departamento Mercedes (Corrientes), con niveles de incidencia de T. padwickii del 16%, 34,5% y 55,75%, respectivamente.
Se realizaron 3 tratamientos: a) arena estéril, b) mezcla arena:tierra 1:1 y c) papel estéril con 8 repeticiones, cada repetición consistía en una bandeja con 50 semillas. Las bandejas se incubaron durante siete días en condiciones de 25 ± 2 ºC y fotoperiodo de 12 h luz, 12 h oscuridad. Se utilizó un diseño estadístico en bloques completos al azar. Los ensayos se repitieron tres veces.
A los siete días de la siembra se retiraron los coleoptilos de las semillas germinadas, que se desinfectaron con hipoclorito de sodio al 1,5% por 10 minutos y se lavaron 3 veces con agua estéril durante 5 minutos cada uno (modificado de Mathur y Kongsdal, 2003). Luego, fueron sembrados en cajas de Petri con medio agar poroto 3%, pH 6, con el agregado de sulfato de estreptomicina (depositando 10 coleoptilos por caja de Petri), e incubados en idénticas condiciones que las descriptas anteriormente.
La eficiencia de transmisión (Et) se determinó aplicando la fórmula T/S*100, donde T corresponde a la incidencia de T. padwickii en los coleoptilos, y S, a la incidencia del patógeno en semilla (Carmona y Reis, 2019). Los valores de Et se transformaron utilizando la fórmula √(x+0,5). Con los resultados obtenidos se realizó un análisis de varianza (ANOVA) con arreglo factorial 3x3 con prueba de Tukey al 5%.
RESULTADOS Y DISCUSIÓN
Los resultados obtenidos en este trabajo confirman que la transmisión del hongo T. padwickii desde la semilla a coleoptilos ocurrió en todos los sustratos y variedades. Esta osciló entre valores de 0,67 a 30,04%, dependiendo de la combinación sustrato-variedad (tabla 1).

Tabla 1
Eficiencia de transmisión de T. padwickii a coleoptilos de distintas variedades de arroz. (Letras distintas indican diferencias significativas α =0,5%).
En los coleoptilos sembrados en el medio de cultivo con agar poroto, se identificó al patógeno por la formación de micelio, conidios y esclerocios negros, globosos, de aspecto reticulado, característicos de T. padwickii (fig. 1).
Figura 1
Coleoptilos de arroz sembrados en medio AP (A, D) con desarrollo de esclerocios típicos de T. padwickii. (B, C, E, F).
Los datos obtenidos en la tabla 1 confirman el efecto interacción sustrato x variedad, el cual resulta más evidente al observar la figura 2, donde la Et (%) es máxima para la variedad Puita INTA CL en el sustrato arena, y para las variedades TAIM e IRGA 424 en el sustrato papel. No obstante, la utilización de la mezcla de arena:tierra sería la más indicada, porque recrea las condiciones reales de transmisión del microorganismo.

Figura 2
Influencia del Sustrato en la Et (%) de T. padwickki en distintas variedades de arroz.
Los datos obtenidos se explican considerando que la transmisión de patógenos de semillas es compleja y dinámica, y es afectado por distintas variables que interaccionan entre sí (Neergaard, 1979; Maude, 1996; Agarwal y Sinclair, 1997; Singh y Mathur, 2004), entre las cuales se pueden mencionar las siguientes: especie cultivada (resistencia varietal), condiciones ambientales (suelo, temperatura y humedad), profundidad de siembra y localización del patógeno en la semilla. A modo de ejemplo, Casa et al. (2012) estudiaron la transmisión de Fusarium verticillioides a plántulas de maíz , demostrando que dicha variable está gobernada por la interacción entre la temperatura y la profundidad de siembra. En tanto si consideramos el efecto del sustrato, Vu y Somsiri (2006) compararon agar-agua, papel y arena estéril en la transmisión de B. oryzae a plántulas de arroz, y demostraron que el agar-agua presenta el valor más alto de Et, seguido por el papel y la arena. En un trabajo similar, pero en semillas de trigo, Martins et al. (2004) demostraron que, si bien no existen diferencias estadísticas entre sustratos, el papel de filtro logró aumentar la eficiencia de transmisión de Pyricularia grisea. El sustrato afecta la eficiencia de transmisión de manera indirecta, a través de las propiedades físicas y químicas que regula (contenido de humedad, contenido de materia orgánica, pH, entre otros) (Casa et al., 2012; Islam et al., 2012). Respecto a la transmisión de T. padwickii Gutiérrez (2010) demostró que la transmisión se puede dar de dos maneras, sintomática en plántulas de arroz al utilizar la arena estéril como sustrato y asintomática cuando utilizó tierra como sustrato.
Uno de los factores de mayor relevancia es la localización del patógeno en la semilla. Al respecto Lovato et al. (2014) demostraron que T. padwickii es capaz de colonizar los tejidos más internos de la variedad Taim, razón por la cual presentó valores de eficiencia de transmisión altos en comparación con las restantes variedades. Según estos autores, las semillas de la variedad Irga 424 son más susceptibles al ataque del patógeno, lo que genera la podredumbre del endospermo y la muerte de embriones, razón que explica los bajos valores de Et (%) con respecto a las variedades Taim y Puita INTA CL.
CONCLUSIONES
Al analizar los resultados logrados en esta investigación se pueden considerar tres conclusiones: a) la existencia de interacción sustrato-variedad; b) la transmisión en todas las evaluaciones realizadas (distintos sustratos) fue asintomática, lo que corrobora los resultados de Suryadi y Kadir (2009) quienes constataron que los daños que produce este hongo estarían asociados a la disminución de altura de la plántula y en el largo de la raíz; y c) una alta incidencia en las semillas no siempre da como resultado una alta eficiencia de transmisión. Tal apreciación es coincidente con Menten (1987), quien afirmó que esta situación se da con frecuencia debido a que no todo el inóculo presente en la semilla se transmite a la parte área de las plántulas.
Este trabajo aporta las primeras evidencias de la compleja dinámica en la transmisión de T. padwickii, por lo que es necesario estudiar a futuro el efecto de otros factores tales como temperatura, diferentes niveles de incidencia, pH, profundidad de siembra, y eficiencia de transmisión a las raíces.
BIBLIOGRAFÍA
AGARWAL, V.K.; SINCLAIR, J.B. 1997. Principles of seed pathology. 3rd ed. CRC Press: Boca Raton, 555 p.
CABI. 2020. https://www.cabi.org/isc/datasheet/4519
CASA, R.T.; REIS, E.M.; KUHNEM JÚNIOR, P.R.; BOLZAN, J.M.; MOREIRA, E.N. 2012. Interação entre temperatura do solo, profundidade de semeadura e tratamento de semente com fungicida na emergência de plantas de milho. Summa Phytopathologica 38, 90-92.
CARMONA, M.A.; REIS, E.M. 2019. Patología de semillas en trigo y cebada. Detección, epidemiología y manejo. 1.ª ed. Ampliada. Vicente López: Editor Marcelo Aníbal Carmona. Buenos Aires. Argentina. 152 p.
CASTAÑO-ZAPATA, J.C. 1985. Microorganismos asociados con el manchado del grano y el efecto sobre algunas etapas de desarrollo de la planta de arroz. Fitopatología Colombiana 11 (2), 21-25.
COSTA, J.L.; DA. S. 1991. Alternaria padwickii e Curvularia lunata: patogenicidade e transmissão por sementes de arroz irrigado. Fitopatol. Bras. 16(1), 15-18.
DIRCHWOLF, P.M.; GUTIÉRREZ, S.A; CARMONA, M.A. 2015. Detección de la biota fúngica asociada al manchado del grano del arroz. xxi Reunión de Comunicaciones Científicas y Tecnológicas, SGCYT, UNNE. Corrientes, Argentina. (Disponible: https://www.unne.edu.ar/trabajando/com2015/CA-AGROPECUARIAS/CA-26.pdf verificado: 28 de mayo de 2021).
DOMÍNGUEZ SANABRIA, J.A.; GRABOWSKI OCAMPO, C.J. 2017. Transmisión y sensibilidad a fungicidas de Stenocarpella maydis y Colletotrichum graminícola en maíz (Zea mays L.). Tecnología Agropecuaria 2 (1), 29-35.
FARIAS, C.R.J.; AFONSO, A.P.S; BRANÇÃO M.F.; PIEROBOM, C.R. 2007. Ocorrência de Alternaria padwickii (Ganguly) em sementes de arroz (Oryza sativa L.) (Poaceae) produzidas em quatro regiões orizicolas do Rio Grande do Sul e seu efeito sobre plântulas. Arq. Inst. Biol. 74, 245-249.
GUTIÉRREZ, S.A. 2010. Monitoreo de enfermedades en semillas de arroz. Detección, cuantificación y transmisión de Alternaria padwickii y Microdochium oryzae. (Tesis Doctoral) Facultad de Ciencias Agrarias, UNNE, Corrientes. http://repositorio.unne.edu.ar/handle/123456789/154
GUTIÉRREZ, S.A.; CÚNDOM, M.A.; CABRERA, M.G.; LOVATO, A.D. 2010a. Enfermedades foliares del cultivo del arroz. Reunión de Comunicaciones Científicas y Tecnológicas, SGCYT, UNNE, Corrientes, Argentina. (Disponible: https://www.researchgate.net/publication/351953584_Enfermedades_foliares_del_cultivo_del_arroz verificado: 29 de mayo de 2021).
GUTIÉRREZ, S.A.; REIS, E.M.; CARMONA, M.A. 2010b. Methods for detection of Alternaria padwickii in rice seed. Journal of Phytopathology 158,523-526.
GUTIÉRREZ, S.A.; CÚNDOM. M.A. 2013. Guía para la identificación de enfermedades del cultivo del arroz (Oryza sativa L.) en la provincia de Corrientes. Ediciones MAVE. Corrientes Capital. 28 p. (Disponible:_https://www.acpaarrozcorrientes.org.ar/Paginas/Guia_de_enfermedades.pdf verificado: 29 de mayo de 2021).
ISLAM, M.S.; VAHAN, Q.S.A.; BUNNARITH, K.; VIANGKUM, S.; MERCA, M.D. 2000. Evaluation of seed health of some rice varieties under different conditions. Botanical Bulletin of Academia Sinica 41,293-297.
ISLAM, M.S.; RAHMAN, H.; PERVEZ, Z.; MAHUND, M.R.; ALAM, A. 2012. Studies on seed borne in rice cultivars grown in non-saline tidal zones of Patuakhali and their effect on seed germination. Bangladesh Research Publication Journal 6,286-290.
LOVATO, A.D.; GUTIÉRREZ. S.A. 2012. Incidencia de Alternaria padwickii en semillas de arroz. xviii Reunión de Comunicaciones Científicas y Tecnológicas, SGCYT, UNNE, Resistencia, Chaco. (Disponible: https://www.researchgate.net/publication/351953182_Incidencia_de_Alternaria_padwickii_en_semillas_de_arroz verificado: 28 de mayo de 2021).
LOVATO, A.D.; GUTIÉRREZ, S.A.; CARMONA, M.A. 2013. Transmisión de Trichoconiella padwickii a coleoptilos de arroz. Tropical Plant Pathology 38 (4), 346-348.
LOVATO, A.D.; GUTIÉRREZ, S.A.; CARMONA, M.A. 2014. Localization of Trichoconiella padwickii in different components or rice grain. Acta Advance in Agricultura Sciences. 2 (09), 12-16.
LOVATO, A.D.; GUTIERREZ, S.A.; CARMONA, M.A. 2020. Cuantificación de Trichoconiella padwickii en semillas de arroz en la provincia de Corrientes. Primer Congreso Argentino de Semillas. Córdoba, Argentina. (Disponible: https://www.researchgate.net/publication/351952653_Cuantificacion_de_Trichoconiella_padwiciii_en_semillas_de_arroz_en_la_Provincia_de_Corrientes verificado: 29 de mayo de 2021).
MAUDE, R. 1996. Seedborne Disease and Their Control: Principle and Practice. CAB International. Wallingford, Reino Unido. 293 p.
MATHUR, S.B.; KONGSDAL, O. 2003. Common Laboratory Seed Health Testing Methods for Detecting Fungi. 3rd. Ed. Copenhague, Dinamarca. 425 p.
MATHUR, S.B.; MALLYA, J.I.; NEERGAARD, P. 1972. Seed-borne infection of Trichoconis padwickii in rice, distribution and damage to seeds and seedlings. Proc. Int. Seed. Test. Ass. 37,803-810.
MARTINS, D.T.; LAVAVORENTE, N.A.; URASHIMA, A.S. 2004. Comparaçao entre métodos de avaliaçao de transmissao de Pyricularia grisea através de sementes em triticale. Fitopatologia Brasileira 29, 425-428.
MENTEN, J.O.M.; BUENO, J.T. 1987. Transmissão de doenças pelas sementes. En: SOAVE, J.; VELOZO, D.A.; SILVA WETZEL, M.M. (Eds.). Patología de Sementes. Fundaçao Cargill. Campinas, SP, Brasil. 164-191 pp.
MEW, T.W.; GONZALES, P. 2002. A Handbook of Rice Seedborne Fungi.International Rice Research Institute. Los Baños, Laguna. 83 p.
MEW, T.W.; MISRA, J.K. 1994. A Manual of Rice Seed Health Testing., International Rice Research Institute. Manila, Philippines. 113 p.
NEERGAARD, P. 1979. Seed Pathology Vol 1. The MacMillan Press Ltd. Londres, Reino Unido. 861 p.
NALLATHAMBI, P.; UMAMAHESWARI, C.; SANDEEP, K.; LAI, C.; MANJUNATHA, C.; BERLINER, J. 2019. Mechanism of seed trasmission and seed infection in major agricultural crops in India. En: KUMAR, R.; GUPTA, A. (Eds.). Seed-Borne diseases of agricultural crops: detection, diagnosis, and management. Springer. 749-790 pp.
OU, S.H. 1985. Rice Diseases. Commonwealth Mycological Institute. Kew, Surrey, Inglaterra. 380 p.
PINEDA, J.B.; COLMENÁRES, O.; MENDEZ, N.; GUTIÉRREZ, L. 2007. Niveles de inóculo de hongos fitopatógenos asociados a la semilla de arroz. Revista Facultad de Agronomía (LUZ) 24, 481-500.
SERFERBE SIGNABOUBO, G.R.; TSOPMBENG, N.; KUIATE, J.R. 2016. Seed-borne fungi associated with rice seeds varieties in Bongor, Chad Republic. Int. J. Curr. Microbiol. App. Sci. 5(12), 161-170.
SINGH, D.; MATHUR, S.B. 2004. Histopathology of Seed-Borne Infections. CRC Press Book. 282 p.
SULTANA, T.; SHAMSI, S.; BASHAR, M.A. 2018. Prevalence of fungi with seeds of twenty BRRI released rice varieties and seed quality analysis. J. Asiat. Soc. Bangladesh, Sci. 44(1),79-89.
SURYADI, Y.; KADIR, T. 2009. Effect of longevity of seedling-inoculation with Trichoconis padwickii on the severity of rice grain discoloration. Journal Agrotropika 14,1-9.
VU, V.B.; SOMSIRI, B. 2006. Seed Borne and transmission of Bipolaris oryzae, the causal pathogen of brown spot of rice. Journal Kasetsart (Nat. Sci.) 40, 353-360.